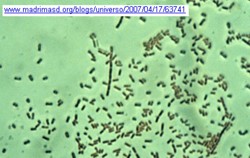

| Moneras
Hongos y Protoctistas
Metafitas
Metazoos
Otros aspectos |

Pulse la imagen para ver la cartelería definitiva
|
| Moneras |

Lactobacilos |

Lactobacilos |

Pseudomonas |

Pseudomonas |

Pseudomonas
|

Pseudomonas |

Nódulos de tuberculosis |

Nódulos de tuberculosis |

Nódulos de tuberculosis |

Bacterias del suelo |
|

Nódulos de Rhizobium |

Rizosfera |

Bacterias sobre hifas |

Nódulos de Rhizobium |
|
|
|
|
|
|
|
Hongos y Protoctistas. |

Hifas de Mucor en el suelo
|

Actinomicetos en el suelo (Streptomices)
|

Micorrizas
|

Descomposición de hojas por los hongos
|

Bacterias sobre hifas |
 Micorrizas |

Escudete |

Escudete |

Negrilla o tizne |

Negrilla o tizne |

Verticilosis |

Verticilosis |
|
|
|
| |

Repilo
|

Repilo
|

Repilo
|

Repilo
|

Repilo
|

Fomes (Casco de caballo, yesquero)
|

Fomes (Casco de caballo, yesquero)
|

Fomes (Casco de caballo, yesquero)
|

Armillaria mellea
|

Omphalotus olearius
|

Omphalotus olearius
|
 Protozoos |

Ameba fagocitando bacterias |

Vorticela en el suelo |

Pequeño arroyo en un olivar |

Charca en un olivar |

Algas de agua dulce |

Algas |

Algas sobre un tronco |

Líquen |

Líquen |

Líquen |

Líquen |

Líquen |

Liquen |

Liquen |

Liquen |

Liquen |

Liquen |
|
|
|

Líquen |

Líquen |

Líquen |
| Metafitas |

Modelo Fam. Compuestas
|
|

Modelo Fam. Borragináceas
|
|

Modelo Fam. Labiadas |
|

Modelo Fam. Oleáceas |
|

Modelo Fam. Crucíferas
|
|

Modelo Fam. Gramíneas |
|
| |
|
|
|
|
|
|
|
|
|
|
|
|
|
|
|
|
|
| Metazoos |
| Plagas del olivo |

Prays (1ª generación -antófaga-)
|

Prays (Orificio de salida en el saco polínico) M.A.P.A. |

Prays (2ª generación -carpófaga-)
|
|

Prays (3ª generación -filófaga-)
|
|

Otiorrinco |

Otiorrinco |

Mosca
|

Mosca |

Mosca |

Cochinilla |

Cochinilla |

Barrenillo |

Barrenillo |

Algodoncillo (cotonet )
|

Algodoncillo (cotonet ) |
Invertebrados del suelo |

Nematodos
|
|
|
|
|
Otros invertebrados del olivar |
|
|
|
|
|
|
|
|
|
|
|
Vertebrados |
|
|
|
|
|
|
|
|
|
|
|
|
|
|
Egagrópilas |
|
|
|
|
|
|
|
|
Huesos |
|
|
Huellas |
|
|
|
|
|
|
|
|
| |
 |
|
| Sonidos |
|

Cartel original |

Cartel ampliado |
|

Montaje definitivo |
Excrementos |
|
|
|
|
|
Otros |
|
|
|
|
|
|
|
|
| Otros aspectos |
| 
|

|

|
|
|
|
|
|
|